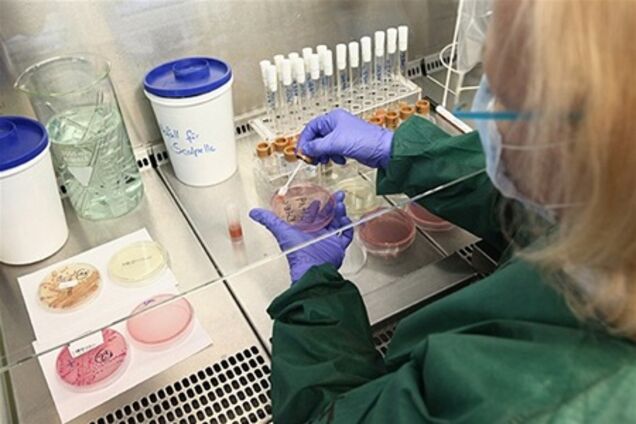
У Німеччині перевіряють нове джерело кишкової інфекції

У Німеччині перевіряють нове джерело кишкової інфекції
Загадкова кишкова інфекція, яка вразила Європу в кінці травня і, від якої загинули вже 30 людей, продовжує поширюватися і вбивати. Перший випадок зараження зафіксовано в Словаччині, а в Німеччині за минулу добу померли троє хворих. Між тим бактерію Esherichia coli (E.coli) знаходять в овочах, які раніше не викликали підозр. Так, у Таїланді виявилися заражені імпортовані з Європи авокадо. Водночас, в Нідерландах виявили бактерії ще одного нового різновиду E.coli, які були знайдені в буряковому бадиллі.
У Німеччині джерело зараження шукають на фермах, в супермаркетах, в сміттєвих баках, в ресторанах. Лікарні на півночі країни ледве справляються з потоком хворих. Тяжкохворі потребують донорської крові та плазми. Німецька влада, продовжуючи пошуки джерела інфекції, взяла під підозру компанію громадського харчування, яка займалася виїзним ресторанним обслуговуванням дня народження в одному з населених пунктів неподалік від Геттінгена 28 травня.
Вісім гостей, які побували на цьому заході, захворіли. При цьому в одного з них підтверджено наявність бактерії Esherichia coli, а у двох інших виявлено гемолітікоуремічний синдром. Це стан, під час якого у пацієнта спостерігається раптове швидке руйнування еритроцитів, викликане гострою нирковою недостатністю, що виникла в результаті часткової або повної непрохідності дрібних ниркових артерій. Але перевірка поки не завершена. Керівництво компанії громадського харчування активно співпрацює з владою.
Самі вони запевняють, що докладають всіх зусиль до швидкого розв'язання проблеми. У відповідь на невдоволення, що відчувається в сусідніх європейських країнах, таку заяву змушена була зробити особисто канцлер ФРН Ангела Меркель. Однак інші держави не тільки критикують німецьку владу, а й змушені тепер боротися з зараженням вже на своїй території.
Крім ФРН, випадки хвороби відзначені в 10 країнах Євросоюзу, а також у США. Майже всі випадки в ЄС або США так чи інакше пов'язані з візитами громадян цих країн на північ Німеччини. У Словаччині в лікарню міста Кошице доставлений 25-річний чоловік з гострою нирковою недостатністю, викликаною кишковою паличкою. Судячи за симптомами, джерело захворювання - саме в Німеччині.
У Таїланді паличкою заражена партія авокадо з Іспанії. Медики чекають остаточних результатів досліджень. Разом з авокадо перевіряють і бельгійську капусту. Уряд азіатського королівства вже звернувся до місцевих жителів із закликом купувати лише місцеві фрукти і овочі.
Як відомо, джерело спалаху досі не вдається визначити. Спочатку передбачалося, що переносником небезпечних бактерій стали салатні огірки з Іспанії, але це припущення не підтвердилося. Потім фахівці заявили, що джерелом інфекції могла стати пророщена соя, але і цю інформацію фахівці спростували. Мутований штам бактерії O104:H4, через який в Німеччині вмирають люди, раніше не був відомий, він стійкий до багатьох антибіотиків.










